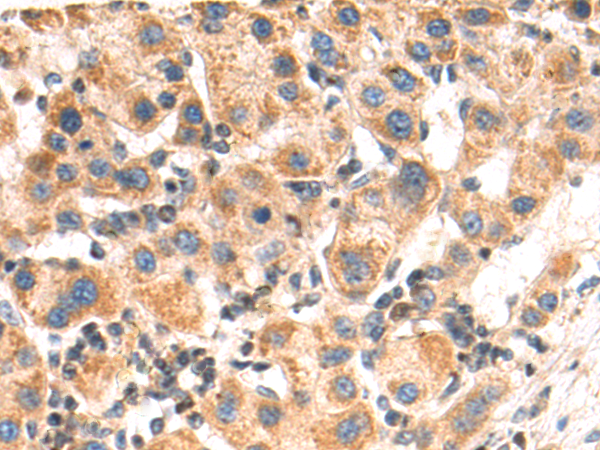

-
分类: 科研抗体货号: P06880别名: NS; NS3; OES; CFC2; RALD; K-Ras; KRAS1; KRAS2; RASK2; KI-RAS; C-K-RAS; K-RAS2A; K-RAS2B; K-RAS4A; K-RAS4B; K-Ras 2; 'C-K-RAS; c-Ki-ras; c-Ki-ras2应用: WB反应种属: Human, Mouse, Rat
-
分类: 科研抗体货号: P06881别名: CP24; HCAI; CYP24; HCINF1; P450-CC24应用: WB,IHC反应种属: Human, Rat
-
分类: 科研抗体货号: P06931别名: LCCS4; MYBPCC; MYBPCS; MYOTREM; ssMyBP-C应用: WB,IHC反应种属: Human, Mouse
-
分类: 科研抗体货号: P06879别名: CTLO; HAMSV; HRAS1; RASH1; p21ras; C-H-RAS; H-RASIDX; C-BAS/HAS; C-HA-RAS1应用: WB,IHC反应种属: Human, Mouse, Rat
-
分类: 科研抗体货号: P06923别名: YWHA1应用: WB,IHC反应种属: Human, Mouse, Rat
-
分类: 科研抗体货号: P06877别名: HD7; HD9; HD7b; HDAC; HDRP; MITR; HDAC7; HDAC7B; HDAC9B; HDAC9FL应用: IHC反应种属: Human, Mouse
-
分类: 科研抗体货号: P06922别名:应用: IHC反应种属: Human
-
分类: 科研抗体货号: P06873别名: B7-H; B7H1; PDL1; PD-L1; hPD-L1; PDCD1L1; PDCD1LG1应用: WB,IHC反应种属: Human
-
分类: 科研抗体货号: P06947别名: HAP; RRB2; NR1B2应用: WB反应种属: Human, Mouse
-
分类: 科研抗体货号: P06915别名: MATE1应用: WB,IHC反应种属: Human

鄂公网安备42018502007531号
鄂公网安备42018502007531号

